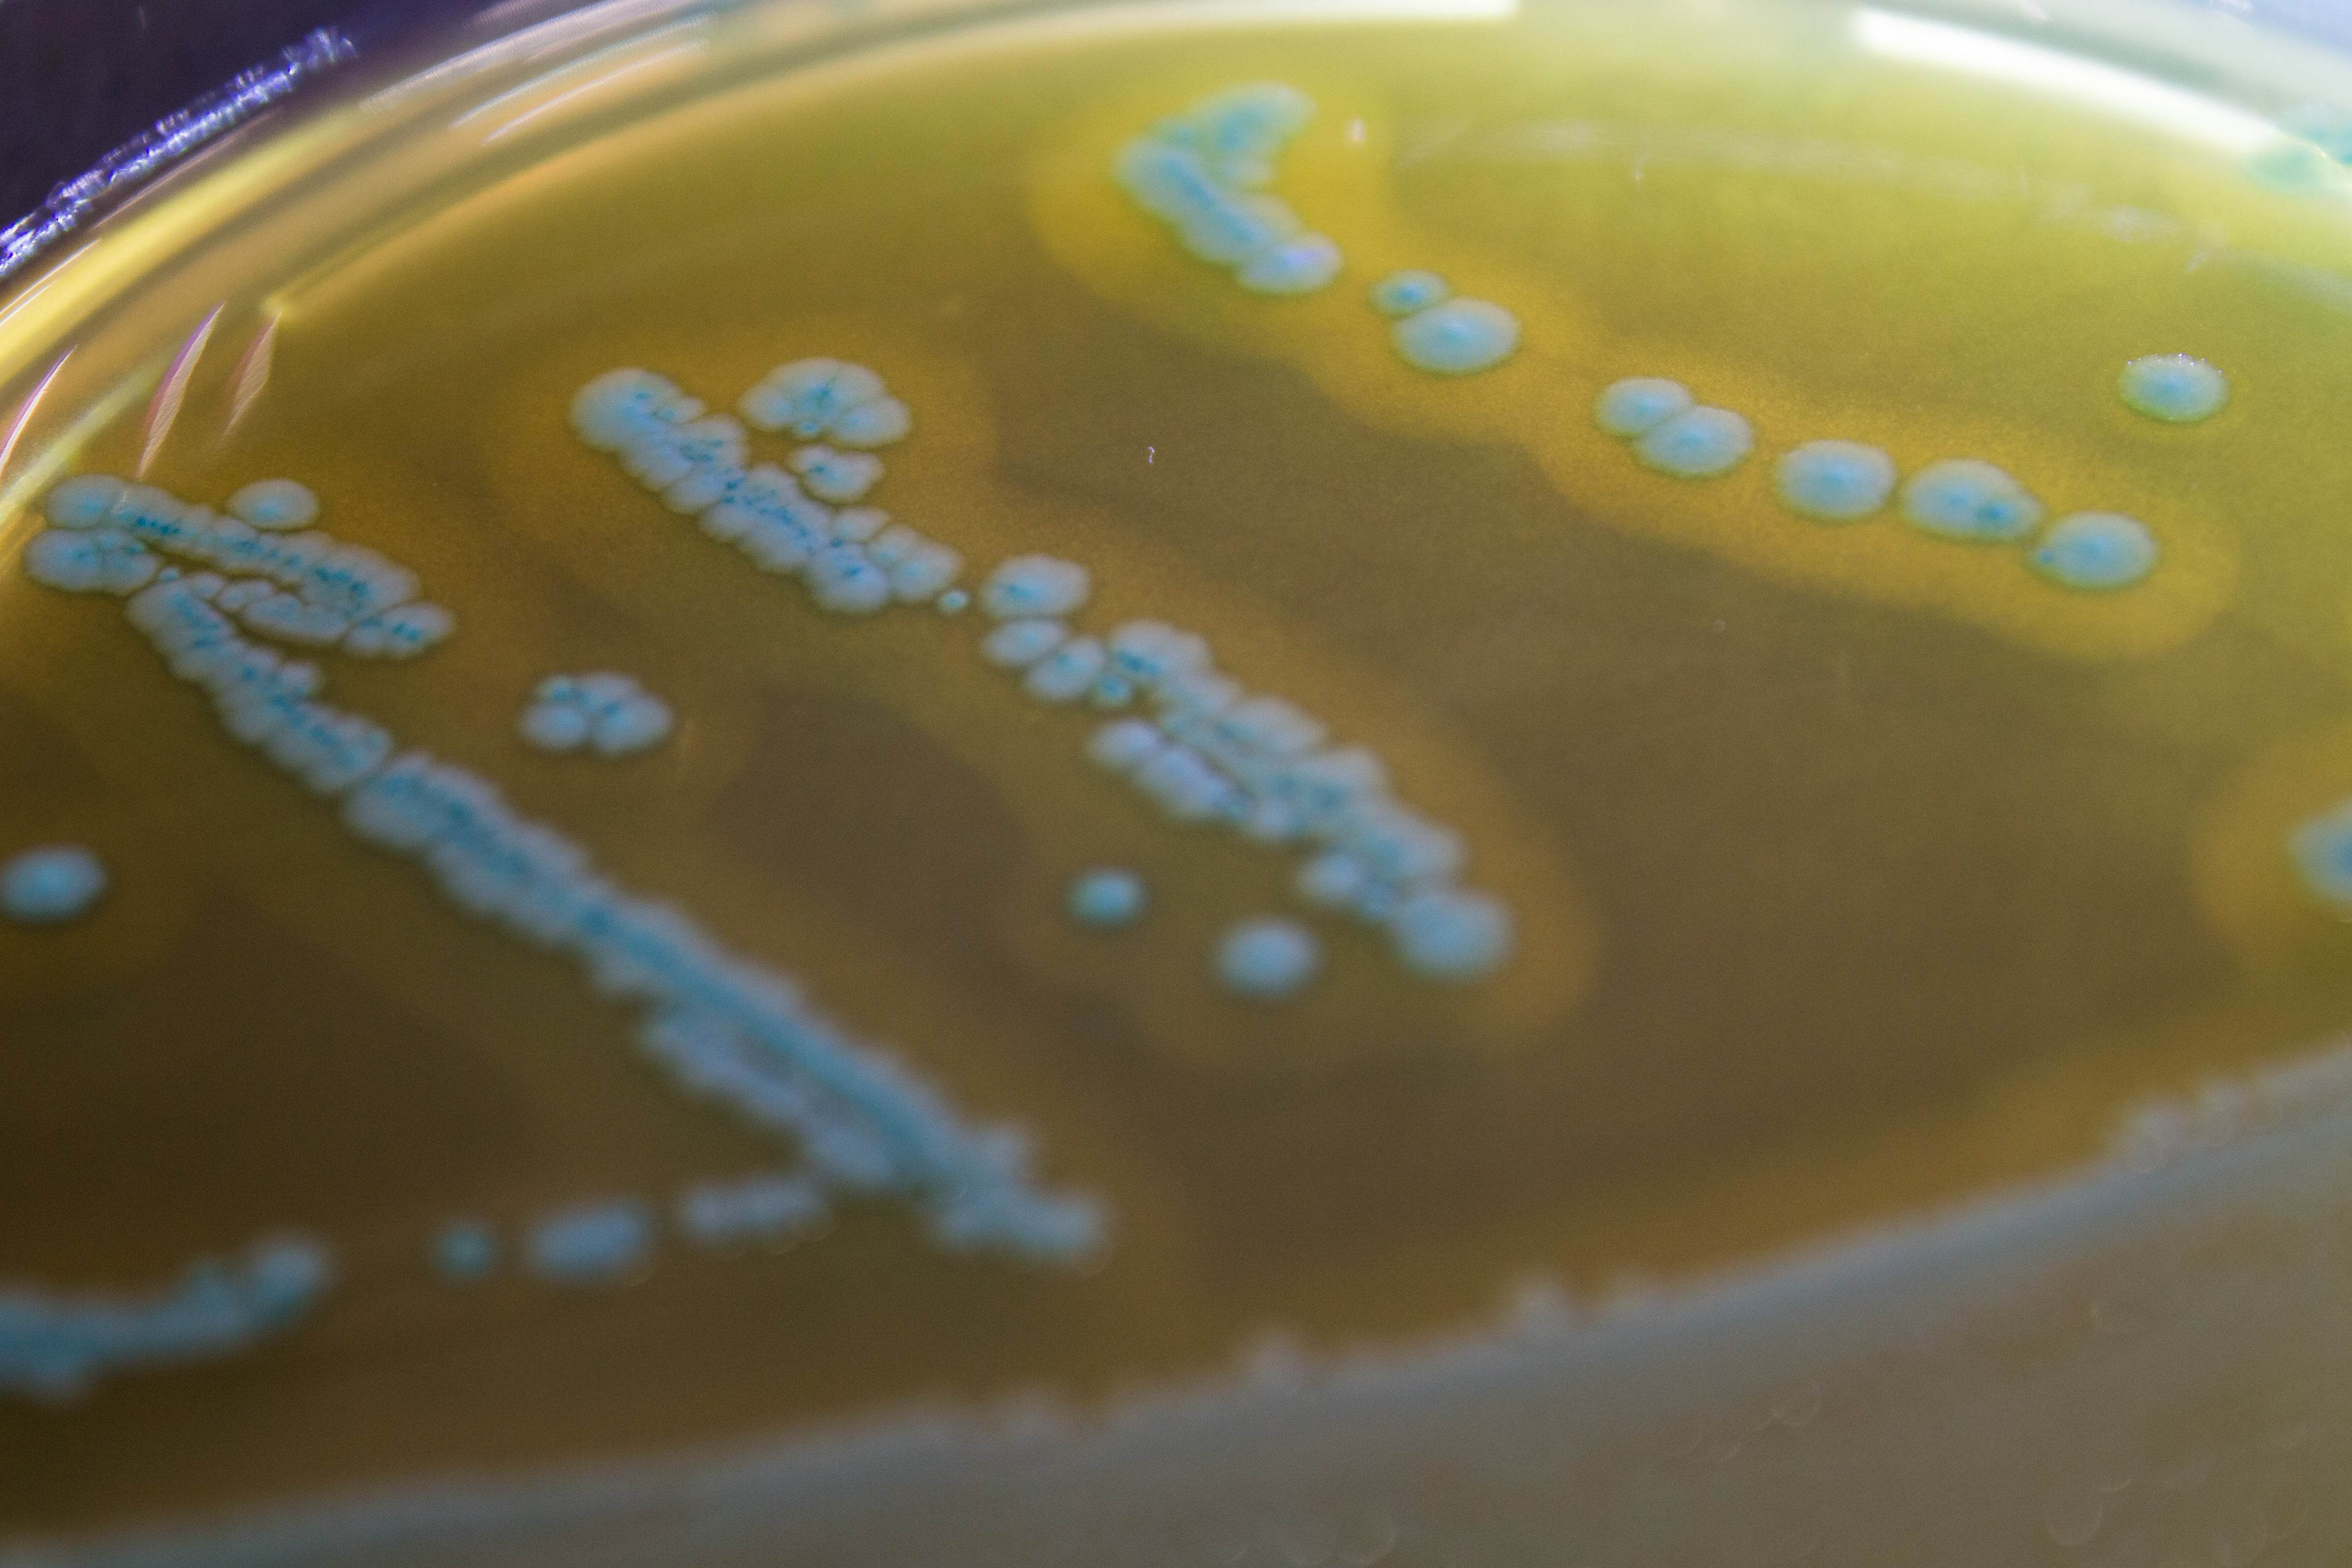

All Products
Showing 1369 - 1392 of 1448 products
Display
View

Liofilchem
Mineral Modified Glutamate Medium - For Microbiology Lab Testing
Sale priceFrom $107.00 CAD


Liofilchem
Mueller Hinton II Agar (Sheep Blood 5%) - For Microbiology Lab Testing
Sale priceFrom $41.00 CAD

Liofilchem
Muller KAUFFMANN TETRATHIONATE NOV.B_MKTTn - For Microbiology Lab Testing
Sale priceFrom $101.00 CAD
Filters (0)